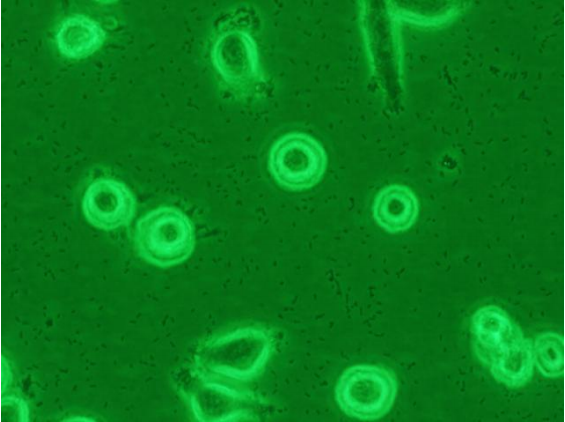

图1. 洋葱佰克霍尔德菌污染 洋葱佰克霍 尔德菌(Burkholderiacepacia)原属假单胞菌属, 广泛存在于土壤及水中,因引起洋葱患病而得 名,是医院感染病原菌之一。
图2. 白色念珠菌污染 常见的细胞污染之一,左侧为倒置显微镜下视图,右侧为革兰氏染色图 片,其中,长梭型的是处于分裂期的链珠菌

图3.链球菌 革兰氏染色

图4. 真菌感染

图5. 支原体污染 煎蛋状和其他形状,左侧:电镜照片(×30k); 右侧:电镜照片(×12k)

图6. 霉菌(丝霉)污染 培养基呈淡紫色,或不变色,但会变得粘稠,一般是来自实验服,并 且具有季节性,像现在这种长蘑菇的季节很容易污染这种菌类。

图7. 细菌污染 倒置显微镜下无法看到细菌的结构(需油镜),污染晚期培养基呈黄色。

图8. 螨虫污染 原代培养皮肤成纤维细胞时常见污染,形态呈杆状,能自主直线游动,速度相 当快,源自小鼠毛发中。

图9. 酵母污染 镜下能隐约看到出芽生殖,肉眼观察可见明显的白色或淡黄色颗粒状的漂浮物, 源自小鼠的皮肤。

细胞培养翻车现场:黑胶虫、支原体、细菌污染合集
版权声明:本文为Bio12345原创文章,遵循CC 4.0 BY-SA版权协议,转载请附上原文出处链接和本声明。